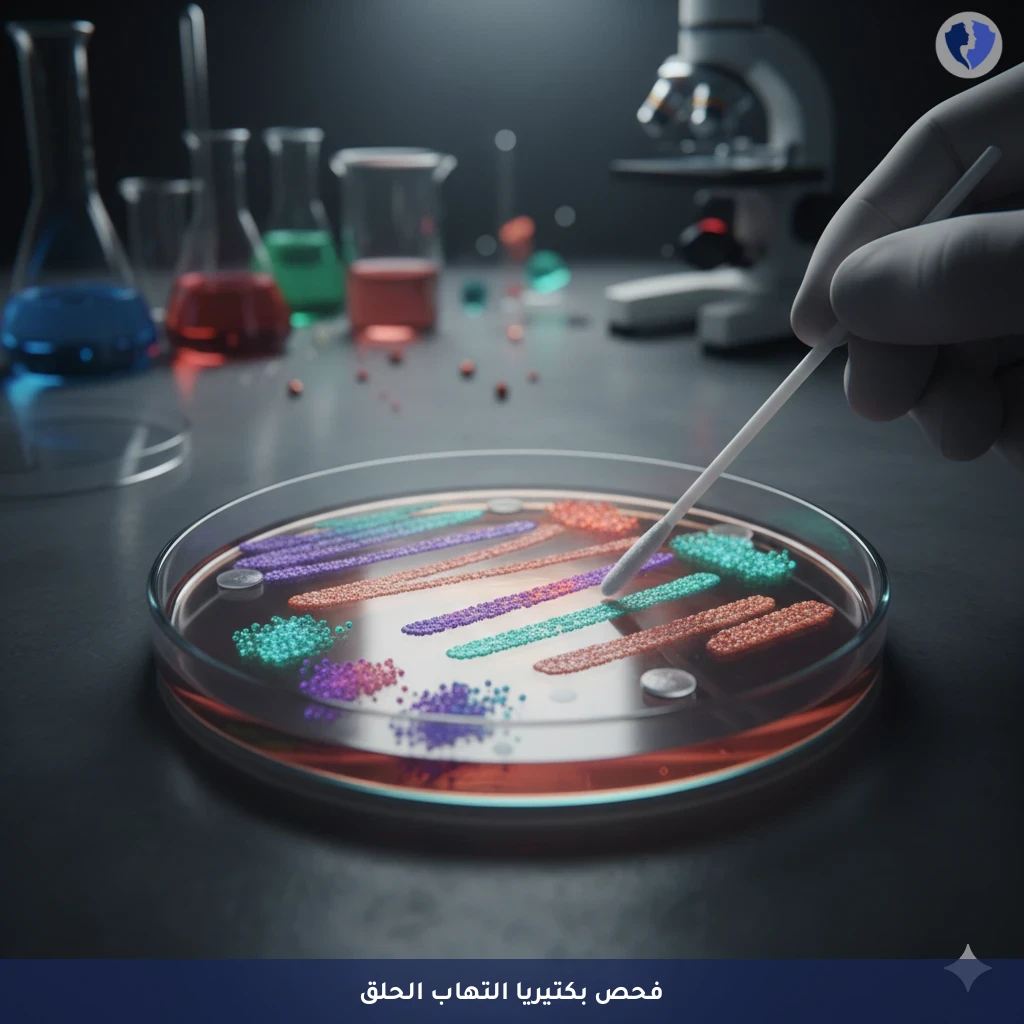
كشف بكتيريا الحلق والمضاد المناسب - مزرعة مسحة الحلق (Throat Swab Culture)

تفاصيل الخدمة
كشف بكتيريا الحلق والمضاد المناسب - مزرعة مسحة الحلق (Throat Swab Culture)
فحص ميكروبيولوجي يتم فيه جمع عينة من مؤخرة الحلق واللوزتين باستخدام مسحة معقمة، ثم زراعتها على أوساط غذائية انتقائية لتشجيع نمو البكتيريا الممرضة، وخاصة المكورات العقدية مجموعة أ (Streptococcus pyogenes). في حالة النمو الإيجابي، يتم إجراء اختبار الحساسية للمضادات الحيوية لتحديد الدواء الأكثر فعالية في القضاء على البكتيريا المعزولة، مما يوجه العلاج الدقيق ويساهم في الوقاية من المضاعفات مثل الحمى الروماتيزمية.